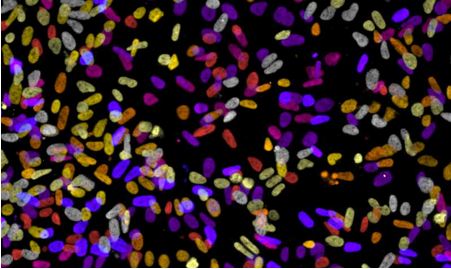

麦克马斯特大学的一个研究小组已经确定了癌症干细胞的一个独特特征,可以被用来杀死致命的细胞,被认为是治疗后癌症复发的原因。了解此功能将有助于将更有针对性的癌症治疗方法提供给合适的患者。
该研究今天发表在科学期刊“细胞化学生物学”上,揭示了现有的药物在杀死癌症干细胞方面是有效的,并解释了如何引导团队发现关于这些细胞如何在人类肿瘤中发挥作用的重要细节。
麦克马斯特干细胞与癌症研究所研究和科学主任首席研究员米克·巴蒂亚(Mick Bhatia)说:“这些药物帮助我们了解生物学。“我们已经倒退回去进行研究,利用诊所使用的一系列药物来了解癌症干细胞可以被杀死的新途径。”
研究人员发现,一种称为 Sam68 的特定蛋白质是癌症干细胞中的重要参与者,并且该蛋白质允许现有药物在癌细胞上起作用,导致它们死亡。
Bhatia 希望这些信息可以用于为受益于他们的患者提供有针对性的治疗,同时避免其他人接受无益的治疗。他认为,如血液癌症如白血病和其他癌症如前列腺,结肠和肾脏的治疗将遵循乳腺癌中的例子,患者接受针对其特定疾病形式的治疗。
Bhatia 说:“就乳腺癌而言,其他研究人员已经发现了使现有药物更有效的新途径,只能给予那些可能根据其具体特征和使用针对这些特征的药物而受益的人。
他说,在开发新药时,平均需要 15 年左右的时间,而且价格标注在数亿美元,定义了现有药物在患者中更好地发挥它们的作用将有助于加速将合适药物引入正确的人的进程。
扫描上面二维码在移动端打开阅读